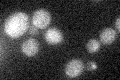
YNR002C
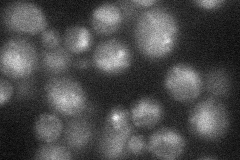
YNR002C
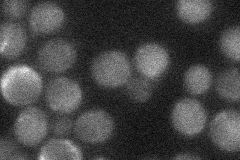
YNR002C
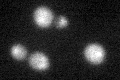
YNR002C
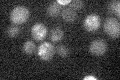
YNR002C

View description
Putative transmembrane protein involved in export of ammonia, a starvation signal that promotes cell death in aging colonies; phosphorylated in mitochondria; member of the TC 9.B.33 YaaH family; homolog of Ady2p and Y. lipolytica Gpr1p
Localization:
Intensity:
Fold change:
Significance:
-
C’ GFP library in SD
below threshold15.45 -
N' NOP1pr-GFP in SD
punctate,vacuole29.9928 -
N' TEF2pr-mCherry in SD

cell periphery,vacuole20.6655 -
N' NATIVEpr-GFP in SD
below threshold21.0336 -
N' TEF2pr-VC and Cyto-VN in SD

below threshold25.9666 -
C’ GFP library in SD+DTT
cytosol14.650.94No -
C’ GFP library in SD+H2O2

cytosol13.890.89No -
C’ GFP library in Starvation Media
cytosol17.231.11No -
C’ GFP library on the background of Pup2-DaMP

below threshold -
C’ GFP library on the background of CCT mutant

below threshold15.19430.983021No
